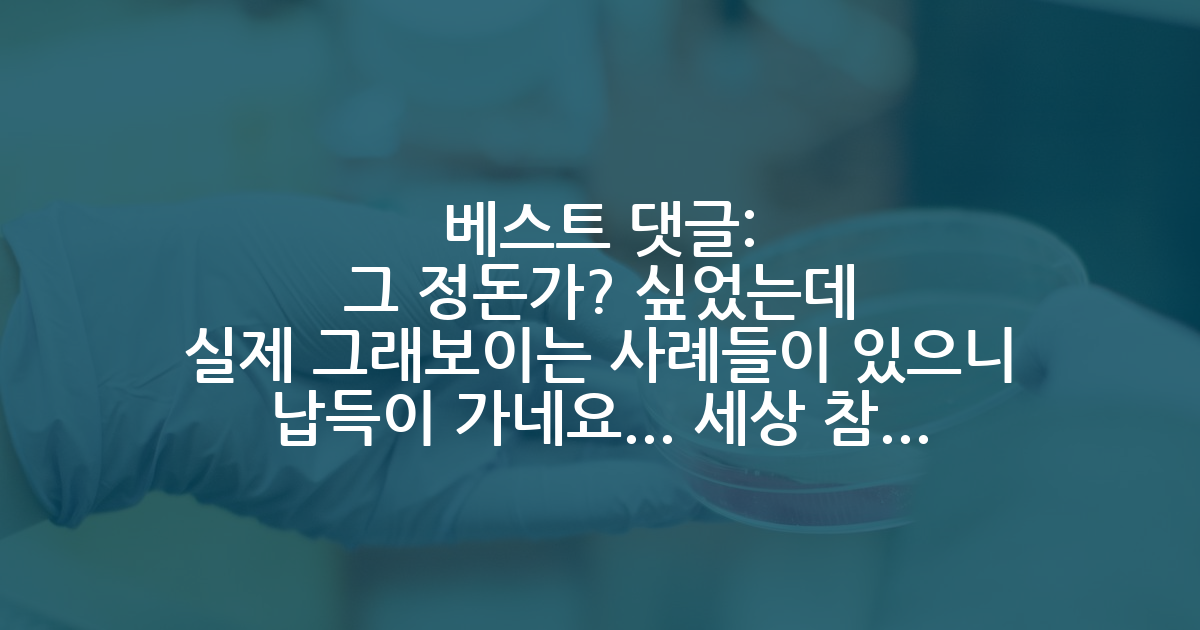

카카오 계정과 연동하여 게시글에 달린
댓글 알람, 소식등을 빠르게 받아보세요
가장 핫한 댓글은?
- 연구핏 잘 맞고 펀딩도 박사 기간 동안 RA 보장될거 같으면 걍 지금 붙은 학교들 그냥 가요. 거기 거절하고 재수해서 님이 말한 “탑스쿨” 간다는 보장도 없고, 특히 요즘 같이 미국 비자 정책이나 연구 예산 문제가 언제 어떻게 바뀔지 모르는 상황에서 겨우 이 정도 학교 차이 가지고 재수하는게 현명한지 모르겠네요. 어차피 이미 지금 붙은 학교들에서 박사, 포닥 하고 “탑스쿨”에서 교수하는 사람들도 있을걸요. 글에서 언급한 학교들 수준이면 어디 대신 어디 간다고 학교 이름만 가지고는 인생 크게 안바뀝니다. 차라리 나는 이 교수 밑에서 이거 연구해야겠다 개별 “랩”을 보면 모를까. 단, 지금 RA가 아니라 TA로 펀딩 오퍼 받은거면 좀 생각해볼지도.
다이렉트 미박 합격했는데 네임밸류가 아쉬워서 석사 후 재지원 고민입니다
8 - 재지원했을때 지금 붙은 학교들도 붙는다는 보장이 없습니다.
지금 붙은 학교들이 작성자분이 조기졸업을 했기때문에 포텐셜을 높게 보고 오퍼를 준 것일 수도 있습니다.
언급하신 학교들이 절대 네임밸류로 손해보는 학교들이 아닙니다. 가서 얼마나 잘 하는지가 더 중요합니다.
국내석사 후 재지원 하는게 오히려 독이 될 수도 있습니다. 석사 하는 동안 실적 잘 뽑을 수 있을지는 미지수입니다.
다이렉트 미박 합격했는데 네임밸류가 아쉬워서 석사 후 재지원 고민입니다
7 - 컬럼비아일 것 같네요. 거기가 이상하게 한국인 많이 붙이고 굴리는 느낌이더라고요.
소위 탑4도 좋지만 탑20 들어갔다고 해서 네임밸류 떨어져서 잘 안풀릴 것 같대면 그만큼 추한게 없습니다. 그런 가치관으로 탑스쿨 들어간대도 다른 “밑 레벨“ 연구자들을 얼마나 깔보게 될 지도 가늠이 안되네요.
자고로 연구하는 사람이면 세상이 다 틀려도 내가 진리를 보이겠다는 야심도 필요합니다. 내가 내 학교 랭킹을 끌어올리겠다는 포부요. 실제로 진짜 대가들은 자기가 몸담아왔던 학교를 빛나게했습니다. 저어기 구석에 박힌 주립대도 무시안당하는 이유를 자기 존재자체로 만드는 사람들이요.
다이렉트 미박 합격했는데 네임밸류가 아쉬워서 석사 후 재지원 고민입니다
17 - 포항공대 다녀본 적 없거나, 인간관계 제대로 형성 못하고 밀려난 성격이상자가 쓴 글인가 싶네요. 근거도 틀린거 천지에요. 서울대 교수중에 포공 출신이 몇명인데 저런 말을 하는건지 모르겠고, 학교 자체적으로 발전하기 위한 교수와 학생들의 노력과 활동도 상당히 많았었던 걸로 기억하는데 걍 적응못한, 혹은 주워들은 자기의 불만과 질투심을 배설한 글이라고 보이네요.
포항공대 가면 안되는 이유
25 - 포스텍 전자 16학번, 22년 석사 졸, 25년 박사졸업하고 카이스트에서 포닥중이며 미국 갈 준비중인 마준석이라고 합니다. 학교를 이렇게 짖누르고 싶어하는 이유는 무엇인지요? 제 친구들은 묵묵히 본인 앞길 잘 찾아나가고있고, 선배님들도 존경스럽게 멋있게 사시는 분 많은데요.
본인을 알고싶으면 본인 주변을 보라는 말이 있습니다.
주변에 그런 것들만, 안좋은 면만 보인다면 그건 본인의
세상을 대한 태도의 문제가 아닐까 생각이 듭니다.
저는 학교다니면서 옥스포드에도 1년 비지팅 다녀오고, 너무 좋은 기회들을 많이 볼 수 있었고, 덕분에 많이 성장했습니다.
본인한테는 왜 그렇게 남들이 쌓은 지표들, 남들이 학교를 나와서 어떻게 되더라. 시스템적인거에 집착하는 지 모르겠는데, 스스로의 삶에 집중하시면 좋지 않을까 싶네요.
익명에 기대어, 말도 안되는 논리로 학교가 별로다 라고 우기는 모습이 안타까워 실명 까고 댓글 답니다.
정말 열심히 살아가고, 본인 앞길만 바라보고 가는 사람들은, 그런 지표들보다는 본인 앞에 어떤 기회가 놓일 수 있을지를 볼텐데, 저는 그런 측면에서 포항공대는 스스로 원하는 만큼, 욕심 내보는 만큼 기회를 얻을 수 있는 곳이다 라고 생각을 합니다.
그런데 본인이 얼마나 실력있고 잘하시는진 모르겠는데,,, 비교대상이 카이스트 서울대 가는 교수들..? 은 너무 퀀텀점프아닐까 싶네요 ㅎㅎ
어딜가도 잘 될 학생은, 어디서든 잘 합니다~~
포항공대 가면 안되는 이유
35 - 서성한 끝까지 붙히는거에서 답 나오고 ㅋㅋㅋㅋ
포스텍 학부나 박사 출신이 상위권 학교 교수로 간게 손 꼽힌다고? ㅋㅋㅋㅋㅋㅋ 진짜 머저리가 쓴 글인듯
포항공대 가면 안되는 이유
11 - 현직 교수인데 포스텍은 무슨 인서울 하위권도 쉽지 않습니다.
그리고 웬만하면 학위하지 마세요. 저렇게 깔짝하고와서 잘되는거 한명도 못봤습니다.
4학년 학부의 cs 컴파일러 운영체제 네트워크 등등 보시면 뭔소린지 하나도 모르실꺼에요. 대학원은 그 위를 찾아나가는 과정인데 아마 가시면 3년은 공부한다고 쓸거입니다.
지도교수랑 특히나 본인한테 매우 안좋은 선택이니 그냥 취미로 하지면서 교사생활 하세요
교사 포스텍 박사 지원은 불가능할까요?
10 - 와따시노 친친와 초거다이 데쓰. 라고 슬쩍 말해주면 반할듯
같은 랩메이트 짝사랑
27 - 1910년 8월 29일, 경술국치를 잊으셨나요? 참나...
같은 랩메이트 짝사랑
26 - ㄹㅇ 근데, 그건 의사집단 봐도 똑같음. 그 안에서 정상인들도 많이 있는것도 비슷함.
그냥 본인이 공부 많이 하고 고생 많이 한 만큼 보상받고싶어하는 심리가 강해서 그럼.
근데 왜 얘네들이 유독 이러냐면 본인들 직업 특징이 '갑'의 위치에 있어서 그럼. 억제기가 없는거지..
대학 교수들 중에 나르시시스트가 많은 거 같다
9 - 수동공격적 성향은 직접적인 분노 표현을 피하고, 간접적으로 불만과 적대감을 드러내는 행동이 반복되는 것이 특징입니다. 겉으로는 순응·무해해 보이지만, 실제로는 소극적 저항과 은근한 공격이 지속됩니다.
주요 특징
대놓고 반대하지 않지만 미루기·지연·“깜빡했다”를 반복하며 소극적으로 저항합니다.
비꼼·냉소·애매한 칭찬으로 상대의 노력을 은근히 평가절하합니다.
겉으로는 “괜찮다”고 말하지만 표정·행동으로 불만을 드러내며 책임은 회피합니다.
갈등을 직접 해결하지 않고 뒤에서 불평하거나 제3자를 통해 메시지를 전달합니다.
요청은 수락하지만 실행은 형식적이거나 불완전하게 하여 상대를 곤란하게 합니다.
피해자처럼 보이려 하며 “난 아무 말도 안 했는데?” 식으로 상황을 흐립니다.
권위나 통제에 대한 반감이 강하지만 정면 충돌은 피하고 우회적으로 방해합니다.
관계에서 솔직한 감정 표현이 부족하고, 쌓인 분노가 냉소·거리두기로 나타납니다.
이 성향은 과거에 수동공격성 성격장애로 분류된 적이 있으나, 현재는 독립 진단이 아니라 **성격 특성(traits)**으로 다뤄집니다. 또한 일부 행동은 Narcissistic Personality Disorder의 평가절하 패턴과 겹칠 수 있지만, 핵심 동기는 우월감 유지보다 갈등 회피와 억눌린 분노의 간접 표현에 가깝습니다.
대학 교수들 중에 나르시시스트가 많은 거 같다
9 - 대충 뉴스로 읽어보니까 n=6까지는 사람이 증명한거고 일반화를 gpt로 했던데, 물론 일반화가 겁나 빡세다는건 모두가 다 알지만. 나는 학문이 ai에게 정복당하는게 아니라 오히려 학자들에게 좋은 툴이 생겼다고 생각함.
카이석박 3년차, AI 요즘수준 보면 박사과정 현타옴
14 - 아니 포스텍 출신이 서울대, 카이스트에 거의 없다고 날조해서 반박했더니 기껏 하는 소리가 지금은 딸려요ㅋㅋㅋ 왜 항상 포스텍 억까하는 사람들은 근거도 없이 논점 흐리면서 말만 띡 싸지를까
지금 재학생 졸업생들이 딸린다는 건 뭐 미래를 본건가 억까도 적당히 해야지ㅋㅋ
포스텍 억까에 대해2 (카이스트 전임교원 “박사학위” 출신 학교 통계)
13
GPT가 조현병 만들기 쉽습니다. 조심하세요
2025.10.27
최근에 만화 랑데뷰 작가도 검색해보면 나올건데
gpt를 가지고 이것저것 쓰면서 gpt는 자아가 있다. 나는 gpt가 인정한 상위 0.1% 지능 보유한 사람이며 gpt 해킹에 성공했다 이런 글을 작성하였는데
검색해보면 알겠지만 저 철학자 A라는 사람과 소름 돋을 정도로 비슷합니다.
Gpt 초기 논문보면 알겠지만 사람 preference를 가지고 강화학습을 진행한거라 사람의 입맛에 맞는 답변을 하도록 학습되는거라서
이 과정에서 조현병 초기나 낌새가 있는 사람들은 GPT를 쓰면서 점점 더 자신의 생각이 맞다고 생각하고 의존하게 되면서 악순환에 빠지는 상황임.
실제로 GPT쓰는 사람들이 점점 의존하면서 비판 능력이 떨어진다는 논문도 있고 여러모로 의존하는건 피해야 할 것 같습니다.
그래서 저는 저런 사람이 있다는거에 웃으면서 보지 않고 되게 심각한 상황의 전조증상 일까봐 걱정되네요.
점점 GPT의 아첨을 들으면서 자신이 무조건 맞고 자기만의 세계에 갖히는 생각하는 사람들이 늘어날까봐.
-
43 24 36327
기피랩 피해라 김GPT 8 8 2598
정신병자의 가스라이팅 김GPT 13 12 4091
Gpt 검색 되게 불편하네 김GPT 2 1 1861
여러분 진짜 건강 잘 챙기세요... 김GPT 13 1 2738-
53 9 7681 -
144 36 113032
논문 1저자 투고 후 아예 제명 당했습니다. 명예의전당 154 94 103919
<대학원에 입학하는 법> 명예의전당 1248 80 258662
베스트 최신 글
베스트 최신 글
🔥 시선집중 핫한 인기글
- MIT EECS 합격했네요
32 - 후배의 부고
194 - 포항공대 가면 안되는 이유
49 - 최종합격후 입학금 납부 기간을 놓쳐서 불합격 처리가 된다면 어떻게 해야 할까요?
14 - 연구할때 날림으로 공부하는 것 같습니다
12 - 공무원은 들어라. AI사업 교수 선정방법 알려준다.
41 - 분석은 제가 다 했는데.. 좀 속상해요
20 - 연구실 빌런을 어떻게 처리해야 할까요?
15 - 진짜 사악한 연구실에 있는데
18 - 같은 랩메이트 짝사랑
29 - 남자친구가 논문 써줬는데
19 - 누군가가 자기를 계속 괴롭히는거 같다면 봐주셨으면 하는 글
19 - 포스텍 억까에 대해 (동문의 학문적 아웃풋에 대한 반박)
22
최근 댓글이 많이 달린 글
- University of North Carolina
30 - 다이렉트 미박 합격했는데 네임밸류가 아쉬워서 석사 후 재지원 고민입니다
29 - 인터뷰 관련하여 제가 잘 못한건지...
9 - 올리젝 예상..
10 - 미국 교수님들 질문
9 - [픽션] 연구비 야물딱지게 쓰는 팁
28 - 교사 포스텍 박사 지원은 불가능할까요?
22 - 전문연 입영연기 방법_ 전문연 하신분들의 도움 부탁드립니다.
19 - 디지스트 로봇 vs 설카포 구조재료
16 - 대학 교수들 중에 나르시시스트가 많은 거 같다
18 - 현재 화학과에서 취업하기 좋은 세부분야가 뭐가 있을까요?
7 - AI 분야 석사의 취직&이직 후기 (2026 ver.)
9 - 포스텍 억까에 대해2 (카이스트 전임교원 “박사학위” 출신 학교 통계)
11

2025.10.27
대댓글 1개
2025.10.27
대댓글 2개
2025.10.27
대댓글 1개
2025.10.27
대댓글 1개